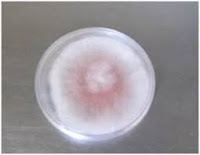

PENGERTIAN
Bioteknologi adalah cabang ilmu yang mempelajari pemanfaatan makhluk hidup (bakteri, fungi, virus dan lain-lain) maupun produk dari makhluk hidup (enzim) dalam proses produksi untuk menghasilkan barang dan jasa.
PENTINGNYA BIOTEKNOLOGI DI DUNIA KEHUTANAN
- Tekanan perdagangan dunia
- Perdagangan hasil kayu dan non kayu yang memerlukan sertifikat pengelolaan hutan secara lestari
- Pembatasan tumbuhan dan hewan berdasarkan jumlah populasi.
- merupakan hasil konvensi internasional antara pemerintah untuk tujuan melindungi spesies-spesies yang terancam punah.
- Pertumbuhan populasi dan permintaan kebutuhan manusia.
- Ketidakseimbangan antara peningkatan jumlah populasi manusia dengan kebutuhan (sandang pangan papan).
- Penurunan luas daratan dan kualitas tanah.
- Sehingga memacu teknologi yang dapat meningkatkan hasil hutan mengikuti peningkatan kebutuhan manusia dengan tetap memperhatikan kelestarian lingkungan (menggunakan biotenologi)
- Berkurangnya penutupan lahan / hutan.
- Perubahan iklim, illegal loging dan kerusakan lainnya terutama yang merupakan dampak praktek-praktek pengelolaan sumber daya alam yang salah berakibat penurunan kualitas hidup dan kehidupan manusia sehingga akan menjadi ancaman intensif.
TINGKAT PERKEMBANGAN BIOTEKNOLOGI KEHUTANAN
Berdasarkan Gambar di samping, perkembangan bioteknologi berada pada wilayak kuning dan orange.
Perkembangan bioteknologi ini merupakan bioteknologi modern, dimana :
- aras rekayasa telah lebih terarah sehingga hasilnya dapat lebih atau bahkan sepenuhnya terkendali.
- Contoh : mutasi gen dan transgenetik (manipulasi genetic), bioteknologi molekuler
Sementara wilayah berwarna biru masih merupakan bioteknologi konvensional, dimana:
- penerapan teknik-teknik biologi, biokimia atau rekayasa masih sangat terbatas sehingga belum mencapai aras rekayasa molecular yang terarah.
- Contoh : propagasi seperti kultur jaringan.
MIKROB DALAM BIOTEKNOLOGI
Fungi
Klasifikasi fungi bersifat dinamis,
- Ascomycota
- Basidiomycota
- Zygomycota
- Chytridiomycota
(Alexopoulus et al. 1996; Webster and Weber 2007)
- Glomeromycota
Ciri umum fungi :
- Eukariotik (memiliki
membran
inti)
- Tidak memiliki klorofil (heterotrof)
- Uniseluler dan multiseluler
- Beberapa memiliki zat warna
- Mendapatkan nutrisi dengan absorpsi
- Bentuknya bermacam-macam
- Dinding sel tersusun
dari zat
kitin
ASCOMYCOTA
Contoh lain :
Trichoderma yang merupakan saprofit kuat sebagai agens dekomposer.
Fusarium (dikenal sebagai fungi pembentuk gaharu).
BASIDIOMYCOTA
Basidiomycota dicirikan membentuk tubuh buah/ badan buah, secara umum memiliki karakteristik seperti digambar.
spora dihasilkan distruktur berbentuk basidium
Contoh Fungi pembentuk ektomikoriza
 |
| Lactarius |
 |
| Boletus |
 |
| Rusulla |
GlLOMEROMYCOTA
kelompok fungi yang bersimbiosis mutualisme dengan tanaman. bentuk asosiasinya adalah mikoriza arbuskul (endomikoriza).
Contoh
 |
| Glomus |
 |
| Acaulospora |
 |
| Gigaspora |
CHYTRIDIOMYCOTA
 |
| Reproduksi |
 |
| Zoospora |
Fungi dicirikan dengan pembentukan zoospora (warna coklat) yang memiliki satu flagel di bagian belakang (warna hialin).
ZYGOMYCOTA
Kelompok fungi yang umumnya saprofit
memiliki pertumbuhan sangat cepat
miselium coenocytic
tahap reproduksi seksual : zygospora
Contoh :
 |
| Mucor sp. |
 |
| Rhizopus sp. |
Isolasi Fungi dari tanah non FMA
Pembuatan suspensi tanah 10-1, 10-2, 10-3, 10-4, 10-5, 10-6, dst.
- Tanah dilarutkan dalam aquades sebanyak 100 ml
- 9 ml aquades dituang dalam setiap tabung reaksi
- tabung reaksi pertama yang berisi 9 ml aquades ditambah 1 ml larutan tanah, dihomogenkan
- tabung reaksi kedua ditambah 1 ml suspensi tanah dari tabung reaksi pertama dan dihomogenkan
- tabung reaksi ketiga ditambah 1 ml suspensi tanah dari tabung reaksi kedua dan dihomogenka,
- begitu seterusnya.
setelah dikulturkan pada media agar dan diinkubasi, selanjutnya dihitung koloni yang tumbuh pada waktu yang ditentukan.
jumlah koloni (CFU) = jumlah koloni yang tumbuh x pengenceran
misalnya jumlah koloni per petri dish 159
seri pengenceran 10 3
maka jumlah koloni adalah 159 x 10 3 cfu atau 1,59 x 10 5 cfu
Cara isolasi fungi/bakteri dari tanah
- Metode Pour plate
- 1 ml atau 0,1 ml suspensi tanah dituang langsung ke Petri dish
- Metode Spread plate
- 0,1 ml dituang ke Petri dish dan di ratakan dengan L-glass
Isolasi FMA dari tanah
 |
| Langkah mengikuti urutan nomor |
Selanjutnya .......